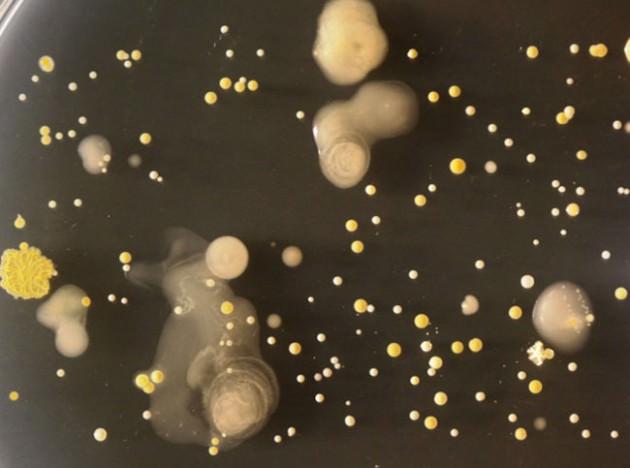
İngiltere'deki Surrey Üniversitesi Mikrobiyoloji bölümü öğrencileri cep telefonlarına yakından bakmaya karar verince bakterileri farkettiler. İnanması zor ama cep telefonlarında tuvaletin 18 katı daha fazla bakteri bulundu.

Cep telefonunda yaşayan canlılar
27.02.2013
15:15
Sanat çalışması gibi görünen bu fotograf aslında bir bakteriye ait.

İngiltere'deki Surrey Üniversitesi Mikrobiyoloji bölümü öğrencileri cep telefonlarına yakından bakmaya karar verince bakterileri farkettiler. İnanması zor ama cep telefonlarında tuvaletin 18 katı daha fazla bakteri bulundu.